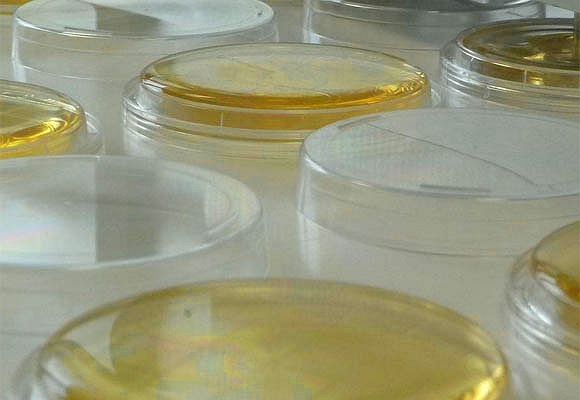

初中高效空氣過(guò)濾器專業(yè)生產(chǎn)廠家
初中高效空氣過(guò)濾器專業(yè)生產(chǎn)廠家
 上海新銳過(guò)濾材料有限公司
上海新銳過(guò)濾材料有限公司電話:021-67627302
手機(jī):18918959380
電子郵箱:82104428@qq.com
地址:上海市松江工業(yè)園區(qū)洞涇分區(qū)洞厙路725號(hào)3號(hào)廠房
為什么說(shuō)在層流環(huán)境無(wú)人的情況下要做微生物含量檢查?在層流地區(qū), 應(yīng)優(yōu)先考慮無(wú)生命的粒子含量, 而對(duì)無(wú)人的環(huán)境下要作微生物含量的檢查, 因?yàn)槲⑸飳W(xué)的方法是不適用檢查過(guò)濾器的淺漏, 和在靜止?fàn)顟B(tài)下不可能發(fā)生由操作人員引起的污染。即使當(dāng)灌裝時(shí)操作人員有錯(cuò)差也只是偶然發(fā)現(xiàn)。
在潔凈室找到的80%~90%的微生物都是由人們帶來(lái)各種菌類,因?yàn)樵跓o(wú)人環(huán)境下沒有此種污染的微生物, 對(duì)于每立方米空氣中微生物計(jì)數(shù)極限無(wú)甚意義。在另一方面, 對(duì)操作環(huán)境下的空氣中微生物計(jì)數(shù)的研究是唯一能說(shuō)明對(duì)產(chǎn)品質(zhì)量危害性的方法, 然而由研究人員所帶來(lái)的污染亦是一項(xiàng)風(fēng)險(xiǎn)。

由研究人員帶來(lái)污染的可能性亦可使結(jié)果失真。現(xiàn)尚無(wú)可參考的采樣、檢驗(yàn)方法, 或評(píng)估定量微生物計(jì)數(shù)測(cè)定法。
由物理方法測(cè)量粒子含量比較可靠、真實(shí)和精確, 應(yīng)有常規(guī)檢查, 生產(chǎn)在線管理和連續(xù)性測(cè)量。
為什么說(shuō)在層流環(huán)境無(wú)人的情況下要做微生物含量檢查由上海新銳過(guò)濾材料整理發(fā)布!

版權(quán)所有Copyright?:上海新銳過(guò)濾材料有限公司 滬ICP備15043222號(hào)-1 過(guò)濾棉廠家 空氣過(guò)濾網(wǎng) 初效過(guò)濾網(wǎng) 初效空氣過(guò)濾器 初效空氣過(guò)濾網(wǎng)
地址:上海市松江工業(yè)園區(qū)洞厙路725號(hào)C廠 漆霧氈 初效空氣過(guò)濾器 袋式過(guò)濾器直銷 漆霧過(guò)濾器 箱式過(guò)濾器G4過(guò)濾棉 空氣過(guò)濾棉 初效過(guò)濾棉
電話:021-67627302/18918958380 2VBB玻纖氈 初效過(guò)濾器 高效過(guò)濾器 中效袋式過(guò)濾器 漆霧氈 烤漆房阻漆網(wǎng) 漆霧過(guò)濾棉 烤漆房地棉 地棉 高效空氣過(guò)濾器 初效空氣過(guò)濾器 中效空氣過(guò)濾器 頂棉